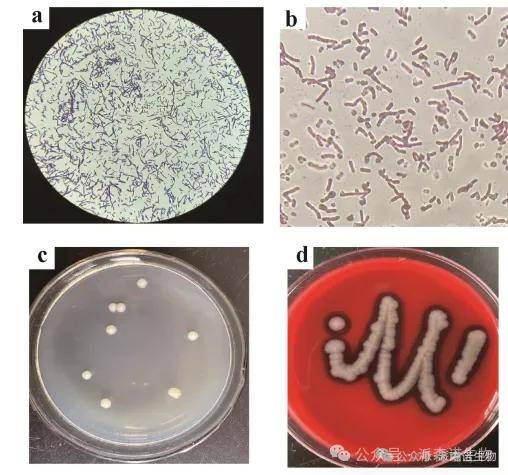

2025-05-26

Highlights
1、本文汇总了食品安全与质量控制热点研究方向及组学研究思路。
2、在食品安全与质量控制领域,多组学技术通过整合微生物组学、基因组学、转录组学、蛋白质组学和代谢组学等多层次数据,提供了更全面、精准的分析手段。
3、派森诺提供多组学检测服务,包括微生物组、基因组、转录组、蛋白组、代谢组及表观调控等,结合多组学联合分析技术,助力食品安全与质量控制科学高效突破,案例成果多多。
食品安全与质量控制是食品工业的基石。随着全球化贸易的加速和消费者对透明化生产的需求升级,传统检测手段(如微生物培养、化学试剂法)已难以应对复杂污染源、隐蔽性危害及个性化质量追溯的挑战。多组学技术(微生物组学、基因组学、转录组组学、代谢组学、蛋白组学等)通过整合多维分子数据,为食品安全风险识别、质量评价和全程溯源提供了革命性工具。本文将解析多组学在食品安全领域的核心应用场景及热点研究方向。
多组学如何重构食品安全防线?
多组学技术以“分子指纹”为核心,突破传统检测的局限性:
精准识别:从基因到代谢物层面解析污染物来源(如致病菌分型、农药残留代谢路径);
动态预警:实时监控食品加工链中的潜在风险(如微生物异常增殖、有毒代谢物积累);
智能评价:建立基于分子标志物的品质分级标准(如新鲜度、营养功能成分)。
以下是当前该领域的热点方向及典型研究思路:
方向1:致病微生物的精准溯源与快检技术
科学问题:如何快速区分食品中致病菌(如沙门氏菌、李斯特菌)的亚型及其毒力基因?
实验设计:
采集污染样本,宏基因组测序获取微生物群落组成;
靶向扩增致病菌毒力基因(如invA、hlyA)并进行三代测序;
代谢组学分析菌株特异性代谢物(如群体感应信号分子)。
分析方案:
构建“菌株-毒力基因-代谢物”数据库,开发CRISPR-Cas12a快速检测探针。
方向2:化学污染物的跨组学筛查与毒性评估
科学问题:如何系统性评估食品中新型污染物(如微塑料、全氟化合物)的毒性机制?
实验设计:
暴露实验:构建污染物梯度浓度处理的细胞/动物模型;
代谢组学检测氧化应激标志物(如MDA、GSH);
蛋白组学分析炎症通路关键蛋白(如NF-KB、COX-2)。
分析方案:
通过KEGG通路富集和分子对接模拟,锁定污染物与生物大分子的相互作用靶点。
方向3:食品掺假与产地溯源的分子标签挖掘
科学问题:如何鉴别高价值食品(如蜂蜜、橄榄油)的掺假成分及原产地?
实验设计:
收集不同产地/品种的原料样本;
非靶向代谢组学筛选特征代谢物(如酚类、萜烯类化合物);
基因组学分析物种特异性SNP位点。
分析方案:
机器学习(如随机森林、SVM)构建产地鉴别模型,筛选标志性分子组合。
方向4:过敏原与致敏性成分的全链条控制
科学问题:如何精准评估加工过程中过敏原(如麸质、花生蛋白)的结构变化与致敏性?
实验设计:
模拟不同加工条件(如热处理、酶解)处理过敏原蛋白;
蛋白组学解析表位结构修饰;
免疫组学检测IgE结合活性变化。
分析方案:
构建“加工参数-表位修饰-致敏性”定量关系模型,指导低敏食品工艺优化。
技术路线

案例分享

蜡样芽孢杆菌GW-01代谢β-氯氰菊酯的机制
Mechanism of β-cypermethrin metabolism by Bacillus cereus GW-01
发表期刊:Chemical Engineering Journal
影响因子:13.273
通讯单位:四川师范大学
组学技术:细菌完成图+转录组+蛋白组
研究背景
农药在保障粮食安全方面发挥着重要作用,但对食品安全、生态保护和人类健康构成潜在威胁。通过微生物活性降解农药,作为一种安全、环境友好、实用的消除农药残留的方法,越来越受到人们的关注。虽然已经从环境中分离出许多拟除虫菊酯(一种农药)降解微生物,并提出了几种降解途径,但总体而言,编码拟除虫菊酯及其代谢产物降解酶的基因仍有待研究。拟除虫菊酯通常被认为是比毒性更强的有机氯和有机磷农药更环保的替代品,其中β-氯氰菊酯(β-CY)占全国拟除虫菊酯市场的50%以上。由于过量喷洒,β-CY残留在水果和蔬菜、河流和土壤中均被检测到,这可能对人类和环境建库产生长期影响。本研究旨在研究从绵羊瘤胃食糜中分离的一种细菌GW-01(蜡样芽孢杆菌)降解β-CY的相关酶基因以及代谢途径。
研究方法
1.实验思路:

2.实验材料:
从甘肃武威市的5岁健康雌性小尾寒羊的瘤胃糜样品中,通过共代谢分离得到β-CY降解菌株——蜡样芽孢杆菌GW-01菌株。
3.测序平台:
Illumina Miseq+Pacbio 、 Illumina HiSeq X Ten。
4.分析内容:
菌株形态和生理生化鉴定、细菌完成图测序、转录组测序、蛋白组测序、代谢组产物检测、基因克隆、载体构建及酶形态学分析等等。
图1:菌株GW-01革兰氏染色反应
图1:菌株GW-01革兰氏染色反应
 图2 基于16S rRNA构建的蜡样芽孢杆菌GW-01与其相关菌株的系统发育树和GW-01全基因组圈图
图2 基于16S rRNA构建的蜡样芽孢杆菌GW-01与其相关菌株的系统发育树和GW-01全基因组圈图

图3:菌株GW-01对β - CY的降解及LB培养基中β - CY暴露后的氧化应激反应


图4:β-CY在GW-01培养物中生物降解的代谢物

图5-1:转录组分析

图5-2 蛋白组分析

图6:基于多组学的降解基因联合分析
研究结论
1. 菌株GW-01从健康母羊瘤胃中分离得到,其个体形态和菌落形态、生理和生理功能均具有显著性差异;
2. 基于16S rRNA基因序列进行系统发育分析,全基因组比较表明该菌株为蜡样芽孢杆菌;
3.不同时间段SOD、CAT、GST活性及T-AOC的变化,表明β-CY诱导小鼠产生氧化应激反应。β-CY的降解似乎是由于最初的酯酶反应,产生3-PBA,被代谢为苯酚和苯甲酸,而在菌株GW-01进一步降解为柠檬酸循环中间体。进一步的这4个基因的表达和活性分析,表明这些基因预测编码的酶负责β-CY及其代谢产物的降解。


